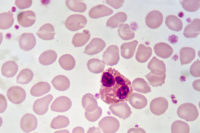

The mission of HR Works is to provide clear, relevant, actionable information on topics that matter to HR professionals through engaging and insightful interviews with experts and thought leaders.
If you want to combat sexual harassment in a meaningful way, you have to get comfortable having uncomfortable conversations. In fact, a major reason sexual harassment in the workplace still takes place has to do with the culture of silence that surrounds it. Additionally, if your employees are not trained to handle situations as they […]
What are your training roadblocks? Perhaps you don’t have the time or resources to roll out the training you need. Maybe you can’t get buy-in from leadership. It could be that your training never sticks, so why bother? In this episode of HR Works Podcast, our guest believes that such roadblocks are far from insurmountable. […]
In this special episode we address the so-called coronavirus. With cases numbering in the tens of thousands across dozens of countries, and hundreds of deaths, this poorly understood disease has created no small amount of chaos and fear. Some of those fears are justified and some not. The U.S. currently has around one dozen confirmed […]
Tackling training can be quite challenging. Other than getting training sticky and making sure it reaches the right people, another major concern concerns how training for one employee might not work so well. In this episode we to discuss an approach to training that takes those differences into account. And, we talk about birds. Merrick […]
Workplace investigations are very serious, usually resulting from unfortunate or unpleasant events. Furthermore, the entire process can easily end up under the scrutiny of a number of legal professionals including employment lawyers and judges. It is very important that HR professionals get their investigations right. This episode’s guest specializes in workplace investigations and is here […]
Whatever your aims, be they improving retention and engagement, upskilling your employees, encouraging innovation, or improving inclusion; training your employees is a critical tool. Everyone wants to know: how do we make sure that training is effective, that it lasts, and that employees engage the training process? This episode’s guest has been part of a […]
With limited resources and time, it can be challenging for employers to initiate annual Family and Medical Leave Act (FMLA) and Americans with Disabilities Act (ADA) training programs for their managers and supervisors. However, the Department of Labor routinely reports that supervisor training is a top area of non-compliance for employers. If organizations don’t properly […]
As an HR professional you know how important diversity and inclusion are. Our guest for this episode specializes in diversity, inclusion, and equity efforts with the specific goal of training a new generation of leaders that can implement major change. This episode’s guest is a leader of the conversation surrounding these efforts. We are pleased […]
In episode 101 of HR Works Podcast, we tackle the performance review: an issue that is sometimes hotly debated. Some organizations still believe in yearly reviews, others on informal discussions, and still others believe that there should be no reviews at all. Today’s guest is an expert on performance reviews, especially the 1 on 1 […]
HR plays a central role in keeping abreast of the constant change that organizations must undergo to survive. Having a strategy for change is critical, but with so many voices out there on how to do that, one can be easily lead astray. With that in mind, we are pleased to celebrate our 100th episode […]